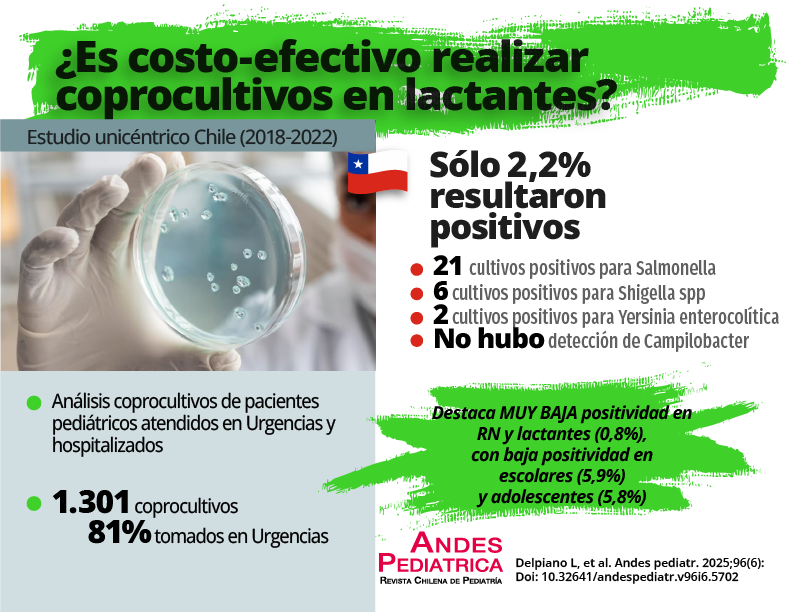

Resumen
La enfermedad diarreica es frecuente causa de morbilidad pediátrica, de variada etiología, siendo el coprocultivo una herramienta de identificación diagnóstica bacteriana.
Objetivo: Evaluar la positividad del coprocultivo en pediatría según edad, origen de solicitud, relación con días de internación y costos.
Pacientes y Método: Revisión de 5 años (2018 a 2022) evaluando la positividad de coprocultivos tomados a pacientes pediátricos en un servicio de urgencia pediátrico, y unidades de hospitalización de un hospital público, además de costos asociados al examen.
Resultados: Se incluyeron 1.301 coprocultivos, 81% de ellos tomados en urgencia y 37,3% en lactantes hospitalizados. Hubo una positividad global de 2,2%, con 29 de ellos positivos, con predominio de Salmonella spp (n = 21) y Shigella spp. (n = 6). No hubo detección de Campylobacter empleando tinción de Hucker. Existió baja positividad en lactantes, mientras que escolares y adolescentes tuvieron una significativa mayor positividad (p = 0.001). Los exámenes tomados en pacientes hospitalizados revelaron una significativa diferencia en la positividad al solicitarse antes de 72 horas de internación. Destaca que, en servicio de urgencia, la mayoría de los pacientes con coprocultivos positivos no fueron hospitalizados.
Conclusión: Se objetiva un bajo rendimiento del examen, sobre todo en lactantes, lo que hace cuestionar la real utilidad de la toma de coprocultivos a todo paciente con gastroenteritis dado su bajo impacto clínico y aumento de costos. Se reitera, además, evitar la solicitud de este examen en hospitalizados posterior a 72 horas desde su ingreso, e incorporar de rutina medios específicos para detección de Campylobacter.

Esta obra está bajo una licencia internacional Creative Commons Atribución 4.0.
Derechos de autor 2025 Luis Delpiano M., José Manuel Campos R ., Felipe Castillo C. , Pablo Correa R., Catalina Le Roy O.